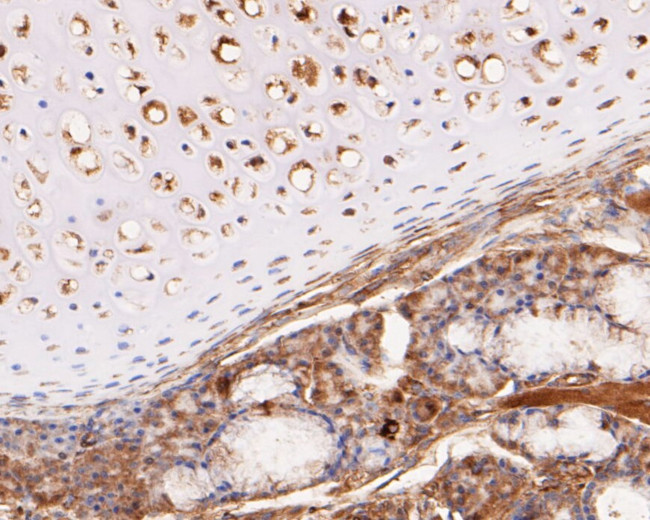
KCNK2 Antibody in Immunohistochemistry (Paraffin) (IHC (P))

Search
Invitrogen
KCNK2 Polyclonal Antibody
{{$productOrderCtrl.translations['antibody.pdp.commerceCard.promotion.promotions']}}
{{$productOrderCtrl.translations['antibody.pdp.commerceCard.promotion.viewpromo']}}
{{$productOrderCtrl.translations['antibody.pdp.commerceCard.promotion.promocode']}}: {{promo.promoCode}} {{promo.promoTitle}} {{promo.promoDescription}}. {{$productOrderCtrl.translations['antibody.pdp.commerceCard.promotion.learnmore']}}
图: 1 / 6
KCNK2 Antibody (PA5-114332) in IHC (P)






Please note: We are reviewing Western blot images included in the antibody testing data in our catalog, including those provided by third parties. Unless expressly labeled or annotated as “raw-unedited”, Western blot images included in the antibody testing data in our catalog may have been edited, optimized or otherwise adjusted for presentation.
产品信息
PA5-114332
种属反应
宿主/亚型
分类
类型
抗原
偶联物
形式
浓度
规格
纯化类型
保存液
内含物
保存条件
运输条件
RRID
靶标信息
TREK-1 is a two-pore-domain background potassium channel expressed throughout the central nervous system. It is opened by polyunsaturated fatty acids and lysophospholipids. As well, it is regulated by various neurotransmitters. It has been shown that alterations in the functioning, regulation, or both of the TREK-1 channel may alter mood. TREK-1 is also activated by volatile anesthetics and has been suggested to be an important target in the action of these drugs. Therefore, this particular K+ channel emerges as a potential innovative target for developing new therapeutic agents for anesthesiology and neurology, such as antidepressants.
仅用于科研。不用于诊断过程。未经明确授权不得转售。
篇参考文献 (0)
生物信息学
蛋白别名: arachidonic acid sensitive tandem pore domain potassium channel; ion transport membrane protein; K2P2.1; kcnk2 {ECO:0000312|EMBL:AAU06141.1, ECO:0000312|Ensembl:ENSRNOP00000003684, ECO:0000312|RGD:621448}; Outward rectifying potassium channel protein TREK-1; outward rectifying potassium channel protein TREK-1 {ECO:0000250|UniProtKB:O95069}; Potassium channel subfamily K member 2; potassium channel subfamily K member 2 {ECO:0000250|UniProtKB:O95069}; potassium channel, subfamily K, member 2; Stretch-activated potassium channel TREK-1; stretch-activated potassium channel TREK-1 {ECO:0000303|PubMed:16248991}; tandem-pore-domain potassium channel TREK-1; trek 1; TREK-1 K(+) channel subunit; TREK-1 K(+) channel subunit {ECO:0000250|UniProtKB:O95069}; Two pore domain potassium channel TREK-1; two pore domain potassium channel TREK-1 {ECO:0000303|PubMed:24196565}; Two pore domain potassium channel TREK1; Two pore potassium channel TPKC1; two pore potassium channel TPKC1 {ECO:0000250|UniProtKB:O95069}
基因别名: A430027H14Rik; AI848635; KCNK2; rTREK1d; TREK; TREK-1; TREK1
UniProt ID: (Rat) Q920B6, (Mouse) P97438
Entrez Gene ID: (Rat) 170899, (Mouse) 16526